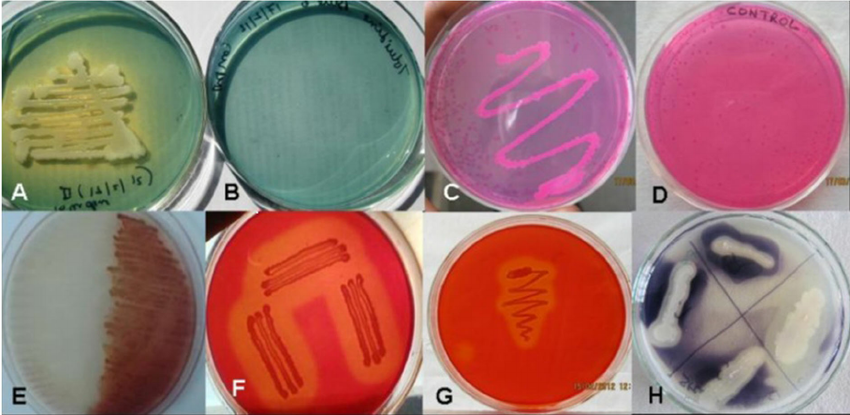
Industrial Enzymes for Cellulosic Sugars and Beyond by Matti Heikkilä

Tag: International Conference on Bio-based Materials
-

One of The Most Important Bioplastics Conference in Europe!
The Bio-based Material Conference is a well-established meeting point for companies working in the field of bio-based chemicals and materials. The conference is one of the largest conferences and industry meeting points in Europe on bio-based chemicals, polymers and plastics.
Written by
·
-

Lignocellulose – Lignin and Cellulose
Presentations given during the International Conference on Bio-Based Materials May 2018
Written by
·
-

Yeast as Platform Technology for Bio-Based Chemicals
Presentations given during the International Conference on Bio-Based Materials May 2018
Written by
·
-

Bio-Based Polymers
Presentations given during the International Conference on Bio-Based Materials May 2018
Written by
·
-

Bio-Based Building Blocks
Presentations given during the International Conference on Bio-Based Materials May 2018 – Live Coverage Tomorrow
Written by
·
-

Feedstock for the Bio-Based Economy
Presentations given during the International Conference on Bio-Based Materials May 2018
Written by
·
-

Bio-Based Materials Policy and Strategy
International Conference on Bio-Based Materials – Policy and Strategy – Live Coverage Tomorrow
Written by
·
-

Program of the International Conference on Bio-Based Materials 2018
Program of the International Conference on Bio-Based Materials May 2018
Written by
·
-

Innovation Award 2018 Bio-based Material of the Year
The Innovation Award for the Bio-based Material of the year 2018 will be awarded during the 11th International Conference on Bio-Based Materials in Cologne.
Written by
·
-

Synthetic Bio-Technology to Boost Green Chemicals Production by Guy Hélin
The start-up focusing on applications of micro-organisms to industry, using the tools developed initially to decode the human genes in labs.
Written by
·
-

Bio-based Phenolics: Development of New Industrial Polymers for Fibre-Reinforced Composites and PU foams by Elena Benedetti
The company started-up in 2013 and is doing R&D on organic polymers, cascading use of resources following a zero waste concept.
Written by
·
-

Turning Dust Into Stone with Bacteria by Martin Spitznagel founder of Dust Biosolutions GmbH
Turning dust into stonewith bacteria by Martin Spitznagel founder of Dust Biosolutions GmbH.
Written by
·
-

Use of Empty Fruit Bunches by Dr Eva Kraner Project mgr at Autodisplay Biotech GmbH
The company focuses on making the production of palm oil more sustainable.
Written by
·
-

HPX Polymers GmBH CEO Dr Uwe Bölz.
HPX develops new bio-degradable polymers based on waste from industrial processes of renewable resources.
Written by
·
-

How to Obtain a Greener Footprint in the Wood Based Industry by Antonio Tourino Couso
Focusing on finding green alternatives to fossil based adhesives and additive incumbents e.g. formaldehyde free NAF adhesive technology based on MDI (using an MDI binding system).
Written by
·
-

Bio-based Polyols From Tall Oil and Rape Seed Oil for the PU Industry by Kristians Grundstoks
The Polyols market is worth 20bn USD and enjoys an 8% annual growth.
Written by
·
-

Development of 1,5-Pentadiamine Based Polyamides by Alex Kedo
The company is focusing on the production of novel specialty chemicals by biological techniques and replacing incumbent product by a bio-based equivalent with similar characteristics.
Written by
·
-

Insects are a Novel Source of Biomaterials by Nathalie Berezina
Ynsects started in 2011. 25 employees today. It claims to be the leader in the rapidly emerging insect based feed industry. Producing high quality chitosan to fill the gap between global demand of reportedly 20kt and 2016 production of 2.6 kt.
Written by
·
-

Biotech Enabled Polysaccharides and Applications by Christian Lenges
Dupont Industrial Biosciences division introduced NUVOLVE* polysaccharides late 2016.
Written by
·
-

Changing Commodities into High Value Specialty Products by Tim Davies
Initial focus of the company was on bio-based butanol and acetone. Now refocused on bio-based product development though advanced fermentation process AFP* .
Written by
·
-

5- HMF as Key Enabler in Bio-Based Chemistry by Thomas Kläusli
Avalon Industries is focusing on the fructose > 5-HMF> FDCA route to enable furan polymers.
Written by
·
-

Gamma-Valerolactone from Bio-Based Levulinic Acid as Alternative to Gamma Butyrolactone by Dr Marijn Rijkers
InnoSyn, founded on May 1st, 2017, is an R&D services spin-off from DSM to specifically focus on chemical programs to go: levulinic acid, fatty acid building blocks, lignin valorization and BIOFOREVER, the EU BBI project.
Written by
·
-

Biosuccinium from Reverdia by Alexander Krapivin
10th International Conference on Bio-bases Marerials – Köln, Germany- May 10-11, 2017
Written by
·
-

5- HMF as Key Enabler in Bio-Based Chemistry by Thomas Kläusli
Company is focusing on the fructose > 5-HMF> FDCA route to enable furan polymers.
Written by
·
-
Industrial Enzymes for Cellulosic Sugars and Beyond by Matti Heikkilä
Core competence of Metgen enzyme engineering and its strategic focus is lignocellulosic biomass in multiple segments.
Written by
·
-

Sustainable Supply Chain and Certification 4.0 by Dr Jan Henke
Sustainable Supply Chain and Certification 4.0 by Dr Jan Henke ISCC Systems GmbH
Written by
·
-

Roundtable on Sustainable Biomaterials by Marcell Peuckert
Roundtable on sustainable Biomaterials by Marcell Peuckert from the RSB foundation
Written by
·
-

Standardization, Labelling and Public Procurement of Bio-based Products by Lara Dammer
Standard is not legally binding but establishes technical specifications and requirements by consensus between the stakeholders of a sector.
Written by
·
-

Emerging Bio-base Economies in Asia: Challenges and Opportunities by Dr. Wolfgang Baltus
Mitrphol, the main sugar supplier in Thailand is one of the driving forces of the bio-economy locally and in Asia at large. Thailand is at the forefront of this regional development.
Written by
·
-

Production capacities of Bio-based polymers by Michael Carus
10th International Conference on Bio-bases Marerials – Köln, Germany- May 10-11, 2017
Written by
·
-

Markets of Bio-Based Building Blocks by Philippa Davies
Graph showing again the decorrelation between the oil price and the price of dextrose in the US to the detriment of the latter in the last two years. Ethylene and propylene prices are actually lower than the price of dextrose in the US and Asia.
Written by
·
-

Policy Updates for the Bio-Economy by Pierre-Alain Schieb
Main policy issues highlighted in the 2003 report on Bio-economy in Europe are still around but being gradually addressed by BBI JU and the fostering of R&D expenses beyond the health sector which used to capture 83% of them.
Written by
·
-

From Renewable Feedstock to Bio-based Solutions – by Lars Börger
Neste, 12bn€ turnover and 5000 employees in 15 countries, has started its migration out of big oil . The largest shareholder is still the Finnish state with a 50,1% stake.
Written by
·
-

Societal ROI of Bio-Based Chemicals and Materials by Dr Willem Sederel
The study is the result of a joint effort by Deloitte, Nova Institute and Delta
Written by
·
-

Bio-Based Industries Joint Undertaking (BBI JU EU): Public -Private Partnership to Support the Transition to a Bio-Based Economy by Pilar Llorente
10th International Conference on Bio-bases Marerials – Köln, Germany- May 10-11, 2017
Written by
·
-

9th Intl Biobased Materials Conference – Day 2
Bio-polymers, lignin utilisation and update on Polyhydroxyalkanoates (PHA) Closing the carbon cycle (Dr Christopher Gürtler, Covestro Germany) Amongst the dream of green chemistry, “use carbon as a raw material” stands at the top of the list. Use CO2 to make sustainable plastics is a dream come true thanks to the co-work of Covestro with the…
Written by
·
-
International Conference on Bio-Based Materials – Day 2
The second day of the International Conference on Bio-based Materials in Köln, Germany, organised by nova-Institute, focused largely on the industry of bio-building blocks, bio- polymers and bio-composites.
Written by
·
-

Innovation Award Bio-Based Material of the Year 2015
Innovation Award “Bio-based Material of the Year 2015” goes to Bayer MaterialScience AG for the first bio-based polyurethane crosslinker for high performance automotive coatings.
Written by
·

